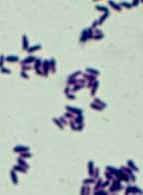

Tour of Microbes  Tour Home | Disease Home | Microbes A to Z | Bio 203 Home |
Corynebacteria are Gram - positive irregular rods; they are non-sporing and often have a club-shaped appearance. Many strains exhibit snapping division. Corynebacteria are chemoheterotrophs often isolated from the human body, and a few are pathogens, including C. diphtheriae (diphtheria). These bacteria produce a toxin (diphtheria toxin) that interferes with eukaryotic protein synthesis.
Domain Bacteria
Phylum Actinobacteria
Class Actinobacteria
Bergey's Manual Volume 5: The Actinobacteria